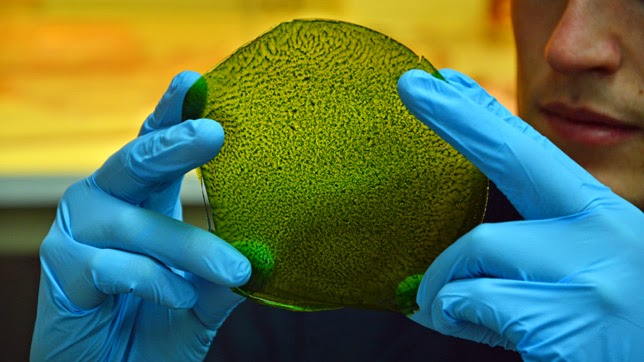

We always get that the water flows down ("down, trickle trickle down") and that "clouds rain down; thunder and lightning sound", but the stage of the water cycle at which the sun cooks the water into invisible droplet-filled vapor is still very mysterious. We do a simple experiment:
1) Soak a paper towel.
2) Hang it with a clothespin somewhere in the room.
3) Go to Art or Music or P.E..
4) Return and retrieve paper towel. What do you notice?
This experiment is always accompanied by shrieks of surprise, excitement and even shock. But the answers to "Where did the water go?" are often very magical, despite the many rehearsals of "See the vapors rise; see them cloud the skies"--because we canNOT see the vapors rise, and it's hard to believe that the water is now in the very air of our room, and indeed that water is EVERYWHair. This year it was concluded that the water vapor went through the little holes in our ceiling tiles to get to the sky, and I could not prove otherwise!
Here's an original that might have been a helpful addition to this week's curriculum, except that we were too busy with "Five Little Pumpkins" and the Spooky Ghost sound /oo/. Boo to you and Happy Halloween too!
Water Becomes You
This water coming into your hands,
it’s old—older than today,
older than you are,
older than the oldest people you know.
This water has been around:
playing over and under the world,
coming up in different wells,
turning through the air into nothing.
This water will make its home in you,
become a part of you,
moving in your very thoughts—
old water welling up in new hands.
HM
2006
all rights reserved
*********************************************************
Go knock on Linda's door at TeacherDance--I bet there are lots of poetreats to be had today!